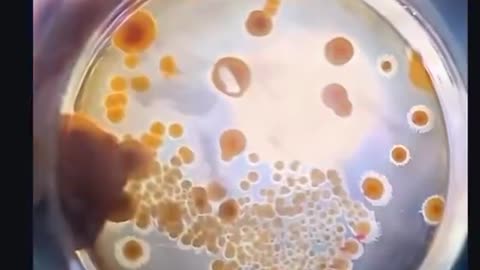
⚠️EMF's are fueling today’s mold crisis❓

-
Children forced to live near cell tower.
 childrenshealthdefenseKristin Phalen gets emotional as she describes how children in her California community could be forced to live just feet away from a massive new cell tower. “In California there aren’t disclosures that tell potential home buyers there are contracts for cell towers.” “The hardest thing about this specific site is this tower is 100 feet from 12 people’s front doors — and four of those people are little kids.” “Loan officers and agents have said if the tower goes up, those people may not be able to sell their homes or move.” “That means those little kids are stuck there.” “There are children who I know will be hurt by this, and they don’t have a chance of getting away from it unless we come together as a community to say, not here.” https://live.childrenshealthdefense.org/chd-tv/shows/good-morning-chd/nyc-mayors-race--medical-freedom--fcc-new-proposed-rules-a-hill-to-die-on/815 views 14 comments
childrenshealthdefenseKristin Phalen gets emotional as she describes how children in her California community could be forced to live just feet away from a massive new cell tower. “In California there aren’t disclosures that tell potential home buyers there are contracts for cell towers.” “The hardest thing about this specific site is this tower is 100 feet from 12 people’s front doors — and four of those people are little kids.” “Loan officers and agents have said if the tower goes up, those people may not be able to sell their homes or move.” “That means those little kids are stuck there.” “There are children who I know will be hurt by this, and they don’t have a chance of getting away from it unless we come together as a community to say, not here.” https://live.childrenshealthdefense.org/chd-tv/shows/good-morning-chd/nyc-mayors-race--medical-freedom--fcc-new-proposed-rules-a-hill-to-die-on/815 views 14 comments -
⚠️This is why you should never use LED 💡 lights in your home❓
 Hot_Topic⚠️This is why you should never use LED 💡 lights in your home❓238 views 3 comments
Hot_Topic⚠️This is why you should never use LED 💡 lights in your home❓238 views 3 comments -
CELEBS GET WIRED UP!!! AT LAST SETTING AN EXAMPLE - Reloaded from STFN
 SNIPERSHORTZAnother Conspiracy Theory Busted! No more larfta at the Plugged in Peeps! 😇59 views 3 comments
SNIPERSHORTZAnother Conspiracy Theory Busted! No more larfta at the Plugged in Peeps! 😇59 views 3 comments -
"Know thy enemy…" How man 5G cell towers within a 3 mi radius of your home?
 Truths Unlimitedhttps://www.antennasearch.com/ Video source: https://t.me/newstfn/418491.48K views 4 comments
Truths Unlimitedhttps://www.antennasearch.com/ Video source: https://t.me/newstfn/418491.48K views 4 comments -
Life Next to a Cell Tower: The Victims’ Perspective
 childrenshealthdefenseHosted by Miriam Eckenfels, with guests Hank Allen, Shari Champagne, Amelia & Courtney Gilardi.1.76K views 6 comments
childrenshealthdefenseHosted by Miriam Eckenfels, with guests Hank Allen, Shari Champagne, Amelia & Courtney Gilardi.1.76K views 6 comments -
⚠️EMF's are fueling today’s mold crisis❓
 Hot_TopicThe real danger isn’t mold itself, it’s the mycotoxins, the toxic gases mold releases122 views
Hot_TopicThe real danger isn’t mold itself, it’s the mycotoxins, the toxic gases mold releases122 views -
IT AIN'T 'LONG COVID' VIOLET, IT'S RADIATION POISONING - Cory Hillis
 Biological MedicineDo you think you have 'Long Covid', or know someone who does? Cory Hillis' research has helped thousands reclaim their vitality by addressing what he calls “subatomic chaos”—the biological impact of electromagnetic fields from Wi-Fi, smart meters, and personal devices-not 'Long Covid'—Sorry Violet! Get Your FREE EMF Radiation Home Test: https://www.emfsol.com/?aff=SGTreport RELATED Research links: https://bioinitiative.org/conclusions/ https://mysterylores.com/news/comparing-emf-exposure-long-covid-symptoms/ https://www.naturalnews.com/044464_cell_towers_EMF_pollution_mental_confusion.html448 views 2 comments
Biological MedicineDo you think you have 'Long Covid', or know someone who does? Cory Hillis' research has helped thousands reclaim their vitality by addressing what he calls “subatomic chaos”—the biological impact of electromagnetic fields from Wi-Fi, smart meters, and personal devices-not 'Long Covid'—Sorry Violet! Get Your FREE EMF Radiation Home Test: https://www.emfsol.com/?aff=SGTreport RELATED Research links: https://bioinitiative.org/conclusions/ https://mysterylores.com/news/comparing-emf-exposure-long-covid-symptoms/ https://www.naturalnews.com/044464_cell_towers_EMF_pollution_mental_confusion.html448 views 2 comments -
Telecom worker explains how cell towers make people sick….
 Biological MedicineTelecom worker explains how cell towers make people sick…. Source @STRANGER THAN FICTION NEWS529 views 1 comment
Biological MedicineTelecom worker explains how cell towers make people sick…. Source @STRANGER THAN FICTION NEWS529 views 1 comment -
IT AIN'T 'LONG COVID' VIOLET, IT'S RADIATION POISONING - Cory Hillis
 SGT ReportChuck Norris says AVOID these 3 Foods Like The Plague, Watch his method by clicking the link here: https://chuckdefense.com/SGT ---- Learn Brooke Burke's FIT for LIFE secret for FREE, HERE: https://tonyprotein.com/sgt Click above! Do you think you have 'Long Covid', or know someone who does? Cory Hillis' research has helped thousands reclaim their vitality by addressing what he calls “subatomic chaos”—the biological impact of electromagnetic fields from Wi-Fi, smart meters, and personal devices-not 'Long Covid'—Sorry Violet! Get Your FREE EMF Radiation Home Test: https://www.emfsol.com/?aff=SGTreport RELATED Research links: https://bioinitiative.org/conclusions/ https://mysterylores.com/news/comparing-emf-exposure-long-covid-symptoms/ https://www.naturalnews.com/044464_cell_towers_EMF_pollution_mental_confusion.html81.1K views 72 comments
SGT ReportChuck Norris says AVOID these 3 Foods Like The Plague, Watch his method by clicking the link here: https://chuckdefense.com/SGT ---- Learn Brooke Burke's FIT for LIFE secret for FREE, HERE: https://tonyprotein.com/sgt Click above! Do you think you have 'Long Covid', or know someone who does? Cory Hillis' research has helped thousands reclaim their vitality by addressing what he calls “subatomic chaos”—the biological impact of electromagnetic fields from Wi-Fi, smart meters, and personal devices-not 'Long Covid'—Sorry Violet! Get Your FREE EMF Radiation Home Test: https://www.emfsol.com/?aff=SGTreport RELATED Research links: https://bioinitiative.org/conclusions/ https://mysterylores.com/news/comparing-emf-exposure-long-covid-symptoms/ https://www.naturalnews.com/044464_cell_towers_EMF_pollution_mental_confusion.html81.1K views 72 comments -
EMF DISRUPTS THE PINEAL
 SusieQ4uEmf’s disrupt your melatonin production causing a profound effect on sleep patterns, increased cancer risk and more.... Protect yourself and your loved ones with the EMF reducing products from our friends at Fix the World Morocco👇👍👇👍👇 https://www.ftwproject.com/ref/471/ #shungite #protectyourfamily #sleepingpods #pendants #phoneshields #pyramids #chargeplates #orgonepyramids279 views
SusieQ4uEmf’s disrupt your melatonin production causing a profound effect on sleep patterns, increased cancer risk and more.... Protect yourself and your loved ones with the EMF reducing products from our friends at Fix the World Morocco👇👍👇👍👇 https://www.ftwproject.com/ref/471/ #shungite #protectyourfamily #sleepingpods #pendants #phoneshields #pyramids #chargeplates #orgonepyramids279 views